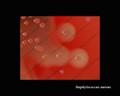
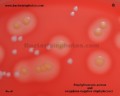
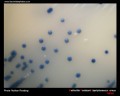

Staphylococcus aureus


Staphylococcus aureus on Columbia agar with 5% defibrinated sheep blood (Bio-Rad™).
Individual colonies on agar are round, convex, and 1-4 mm in diameter with a sharp border. On blood agar plates, colonies of Staphylococcus aureus
are frequently surrounded by zones of clear beta-hemolysis. The golden appearance of colonies of some strains is the etymological root of the bacteria's name; aureus meaning "golden" in Latin.
Methicillin-resistant strains of Staphylococcus aureus (i.e. MRSA) often have only weak or no beta-hemolysis and special cultivation media with oxacillin, mannitol and NaCl for their isolation are used. MRSA is able to grow on this media and produce colonies
of certain color, depending on used pH indicator (in this picture pink).
Staphylococcus aureus may occur as a commensal on human skin; it also occurs in the nose frequently (in about a third of the population) and throat less commonly. The occurrence of S. aureus under these circumstances does not always indicate infection and therefore does not always require treatment (indeed, treatment may be ineffective and re-colonisation may occur). It can survive on domesticated animals such as dogs, cats and horses. S. aureus can infect other tissues when barriers have been breached (e.g., skin or mucosal lining). This leads to furuncles (boils) and carbuncles (a collection of furuncles). In infants S. aureus infection can cause a severe disease Staphylococcal scalded skin syndrome (SSSS). Deeply penetrating S. aureus infections can be severe. Prosthetic joints put a person at particular risk for septic arthritis, and staphylococcal endocarditis (infection of the heart valves) and pneumonia, which may be rapidly spread.
Staphylococcus aureus basic characteristics
- GRAM-POSITIVE COCCI IN CLUSTERS
- NONMOTILE
- NON-SPORE-FORMING
- CATALASE: POSITIVE
- OXIDASE: NEGATIVE
- FACULTATIVELY ANAEROBIC
Identification of Staphylococcus aureus
- production of coagulase (free coagulase)
- presence of clumping factor (cell-bound coagulase)
- sodium chloride tolerance (7.5%)
- mannitol fermentation
- hyaluronidase production (positive decapsulation test with S.equi)
Antibiotic treatment of Staphylococcus aureus infections
IF SUSCEPTIBLE:
- ampicillin/sulbactam
- amoxicillin/clavulanate
- oxacillin
- nafcillin
- cefazolin
- ceftriaxone
- Macrolides
- Clindamycin
- Trimethoprim-Sulfomethoxazole(TMP-SMX)
- vancomycin
- vancomycin
- teicoplanin
- linezolid
- quinupristin/dalfopristin
- TMP-SMX
- rifampicin
- List of antibiotics (Wikipedia)
- Johns Hopkins ABX Guide
- Stanford.edu
- EUCAST (detection of resistance mechanisms)
ALTERNATIVES:
MRSA
Staphylococcus aureus colonies on agar cultivation media
Staphylococcus aureus on blood agar












Staphylococcus aureus beta-hemolysis

Staphylococcus aureus yellow pigment













Staphylococcus aureus without yellow pigment (staphyloxanthin)


Clumping factor (cell-bound coagulase) and free coagulase

Natrium chloride tolerance (7.5-10%) and mannitol fermentation


Lecithinase production and lipase activity on Baird Parker agar


Hyaluronidase production (decapsulation test with S.equi ssp. zooepidemicus)


Staphylococcus aureus MRSA

Staphylococcus aureus biofilm formation


Staphylococcus aureus Gram-stain





Staphylococcus aureus miscellaneous





Staphylococcus aureus 3D

Useful Links
WIKIPEDIACENTERS FOR DISEASE CONTROL AND PREVENTION (CDC)
Todar's Online Textbook of Bacteriology
E-MEDICINE
www.antimicrobe.org
Microbe Wiki (the student-edited microbiology resource)
www.vetbact.org
Merck Manual
Yuri's blog
